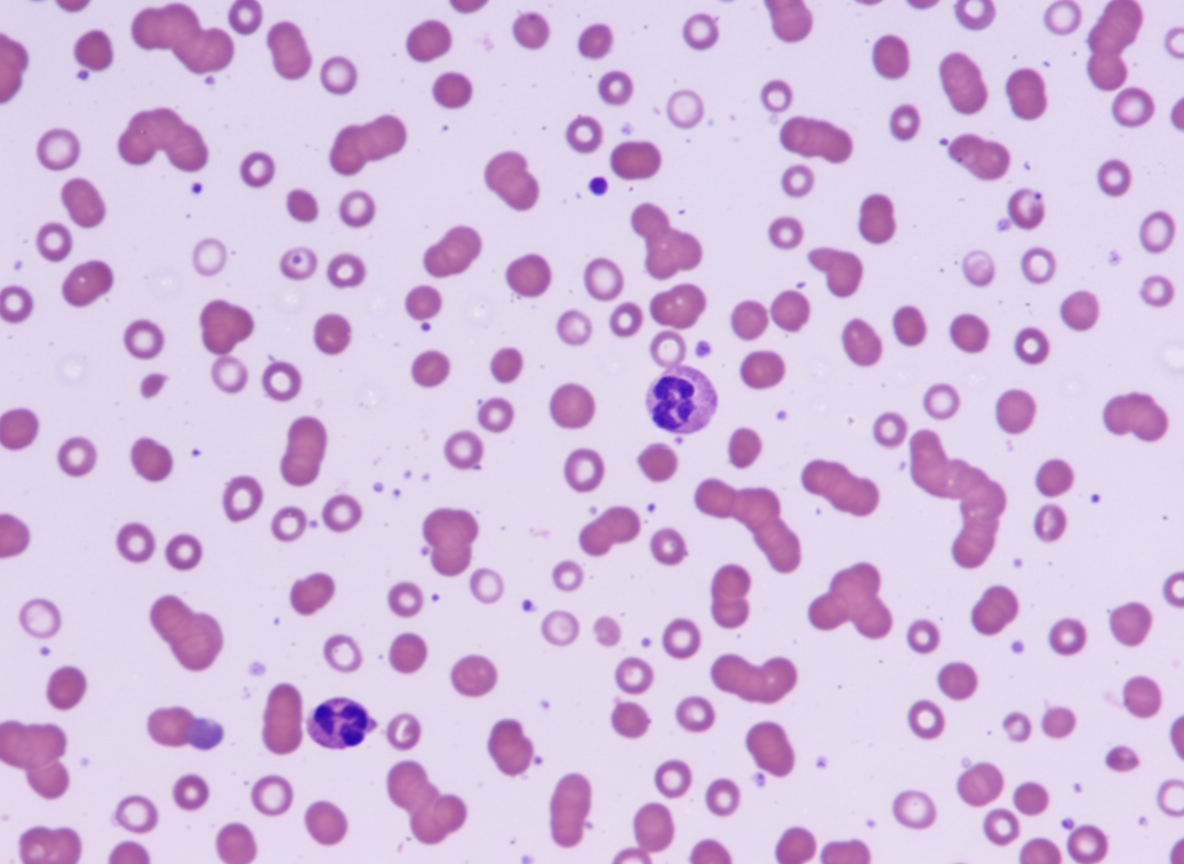
Image for question 789

Prolonged prothrombin time is seen in which of the following conditions?
What is the most common extranodal site for non-Hodgkin's lymphoma?
Leukemoid reaction is seen in which of the following conditions?
Regarding G6PD deficiency, which of the following is true?
ALL L3 cells resemble which of the following?
ALL, morphology, is a malignancy arising from which cell lineage?
What is a common complication seen in polycythemia vera?
Which of the following is the binding site for the von Willebrand factor multimers on the platelets?
A 45-year-old male presents with bony pain, with no history of trauma or drug abuse. Investigations revealed an ESR of 140 mm/hr and Hb of 6 gm/dL. A peripheral smear is shown below. What type of chromosomal abnormality is associated with a favorable prognosis in this patient?
Which of the following disorders has the potential to develop myeloid leukemia?
Explanation: **Explanation:** The **Prothrombin Time (PT)** measures the integrity of the **Extrinsic** and **Common pathways** of the coagulation cascade. It specifically evaluates Factors **VII** (Extrinsic), **X, V, II (Prothrombin), and I (Fibrinogen)** (Common) [1]. **Why Factor VII deficiency is correct:** Factor VII is the unique component of the extrinsic pathway. Since PT is the primary screening test for the extrinsic pathway, any deficiency or inhibition of Factor VII will result in an isolated prolongation of PT, while the Activated Partial Thromboplastin Time (aPTT) remains normal. **Analysis of Incorrect Options:** * **Haemophilia A (Factor VIII deficiency) & Haemophilia B (Factor IX deficiency):** These factors are part of the **Intrinsic pathway**. Deficiencies in these factors lead to a prolonged **aPTT**, while the PT remains normal [3]. * **Thrombocytopenia:** This is a quantitative disorder of **platelets** (primary hemostasis). Coagulation studies like PT and aPTT measure secondary hemostasis (clotting factors) and are typically **normal** in isolated platelet disorders. **High-Yield Clinical Pearls for NEET-PG:** * **Shortest Half-life:** Factor VII has the shortest half-life (approx. 6 hours) among all clotting factors [2]. Therefore, PT is the first lab value to become deranged in **early liver disease** or **Vitamin K deficiency** [1]. * **Warfarin Monitoring:** PT (reported as INR) is used to monitor Warfarin therapy because Warfarin inhibits the synthesis of Vitamin K-dependent factors (II, VII, IX, X), with Factor VII being affected first [2]. * **Isolated Prolonged PT:** Always think of Factor VII deficiency or early Vitamin K deficiency/Warfarin use. * **Isolated Prolonged aPTT:** Think of Hemophilia A, B, or Factor XI deficiency. **References:** [1] Cross SS. Underwood's Pathology: A Clinical Approach. 6th ed. Common Clinical Problems From Blood And Bone Marrow Disease, pp. 624-625. [2] Cross SS. Underwood's Pathology: A Clinical Approach. 6th ed. Common Clinical Problems From Blood And Bone Marrow Disease, pp. 582-583. [3] Cross SS. Underwood's Pathology: A Clinical Approach. 6th ed. Common Clinical Problems From Blood And Bone Marrow Disease, pp. 622-623.
Explanation: **Explanation:** In Non-Hodgkin Lymphoma (NHL), approximately 25–40% of cases arise from extranodal sites. The **Gastrointestinal Tract (GIT)** is the most common overall extranodal location, and within the GIT, the **Stomach** is the most frequent site (accounting for 50–60% of gastric lymphomas) [1]. **Why the Stomach is Correct:** The majority of primary gastric lymphomas are either **Diffuse Large B-Cell Lymphomas (DLBCL)** or **Marginal Zone B-cell lymphomas of MALT type (MALToma)**. The latter is strongly associated with chronic *H. pylori* infection, which induces the formation of organized lymphoid tissue (MALT) in the gastric mucosa, providing the substrate for neoplastic transformation [1]. **Analysis of Incorrect Options:** * **Liver:** While the liver is frequently involved in systemic/advanced lymphoma (secondary involvement), primary hepatic lymphoma is extremely rare (<1% of extranodal lymphomas). * **Spleen:** The spleen is considered a peripheral lymphoid organ. While it is often involved in nodal lymphomas (like CLL/SLL or Splenic Marginal Zone Lymphoma), it is not the most common "extranodal" site by definition. * **Brain:** Primary Central Nervous System Lymphoma (PCNSL) is uncommon in the general population, though its incidence is higher in immunocompromised patients (e.g. HIV/AIDS). **High-Yield NEET-PG Pearls:** * **Most common NHL subtype (overall):** Diffuse Large B-Cell Lymphoma (DLBCL). * **MALToma Pathogenesis:** Associated with *H. pylori* and the **t(11;18)** translocation [1]. * **Waldeyer’s Ring:** The second most common extranodal site for NHL. * **Treatment Note:** Early-stage gastric MALToma can often be cured solely by *H. pylori* eradication therapy [2]. **Note on Carcinoids:** Although many GI tumors exist, carcinoids are primarily found in the small intestine, further differentiating them from the gastric-predominant lymphoma [2]. **References:** [1] Cross SS. Underwood's Pathology: A Clinical Approach. 6th ed. Common Clinical Problems From Alimentary System Disease, pp. 356-357. [2] Kumar V, Abbas AK, et al.. Robbins and Cotran Pathologic Basis of Disease. 9th ed. The Gastrointestinal Tract, pp. 780-781.
Explanation: **Explanation:** A **Leukemoid Reaction** is defined as a reactive increase in the total leukocyte count (typically >50,000/µl) with a significant "shift to the left," mimicking leukemia but occurring in response to an underlying non-neoplastic or extra-hematologic condition. **1. Why Bronchogenic Carcinoma is Correct:** While acute infections are the most common cause of leukemoid reactions, certain solid tumors—most notably **Bronchogenic Carcinoma**—are classic causes of a **Myeloid Leukemoid Reaction**. This occurs due to the production of Colony Stimulating Factors (G-CSF or GM-CSF) by the tumor cells or as a paraneoplastic response to extensive tissue necrosis and bone marrow micrometastasis. In the context of this specific question, Bronchogenic Carcinoma is a high-yield association frequently tested in postgraduate exams [1]. **2. Analysis of Other Options:** * **Acute Infection:** While severe infections (e.g., pneumonia, septicemia) cause leukemoid reactions, they are generally considered "common" triggers [1]. In many MCQ formats, if a specific malignancy like Bronchogenic Carcinoma is provided, it is often the intended answer to test the student's knowledge of paraneoplastic syndromes. * **Myelomatosis (Multiple Myeloma):** This typically presents with a **Leukoerythroblastic picture** (immature white cells and nucleated RBCs) due to marrow infiltration, rather than a pure leukemoid reaction. * **Hemorrhage:** Acute massive hemorrhage can cause a transient rise in WBCs (leukocytosis), but it rarely reaches the threshold of a leukemoid reaction (>50,000/µl) [1]. **Clinical Pearls for NEET-PG:** * **LAP Score:** The Leukocyte Alkaline Phosphatase (LAP) score is **elevated** in a leukemoid reaction but **decreased** in Chronic Myeloid Leukemia (CML). * **Morphology:** Look for **Döhle bodies**, toxic granulations, and cytoplasmic vacuoles in neutrophils, which favor a leukemoid reaction over CML. * **Common Causes:** Severe infections (TB, Pertussis), severe hemolysis, and visceral malignancies (Lung, Colon, Kidney) [1]. **References:** [1] Cross SS. Underwood's Pathology: A Clinical Approach. 6th ed. Common Clinical Problems From Blood And Bone Marrow Disease, pp. 580-581.
Explanation: **Glucose-6-Phosphate Dehydrogenase (G6PD) deficiency** is the most common enzyme deficiency involving the Hexose Monophosphate (HMP) shunt. This pathway is critical for generating **NADPH**, which maintains glutathione in a reduced state to protect RBCs against oxidative stress. 1. **Why Option B is Correct:** In the absence of G6PD, oxidative stress (triggered by infections, fava beans, or drugs like Primaquine) causes hemoglobin to denature and precipitate into **Heinz bodies**. As these RBCs pass through the splenic sinusoids, splenic macrophages "pluck out" these inclusions. This process leaves a characteristic semi-circular defect in the cell membrane, known as **Bite Cells (Degmacytes)** [1]. 2. **Why Other Options are Incorrect:** * **Option A:** G6PD deficiency is an **X-linked recessive** disorder, primarily affecting males [2]. * **Option C:** It provides a survival advantage against **Falciparum malaria**, not Kala-azar. The parasite cannot thrive in an environment with high oxidative stress and premature RBC clearance. * **Option D:** Enzyme levels are **inversely proportional** to the age of the RBC [1]. Reticulocytes and young RBCs have the highest enzyme activity, while older cells are most deficient and susceptible to hemolysis [1]. **High-Yield Clinical Pearls for NEET-PG:** * **Diagnosis:** The screening test is the **Fluorescent spot test**. The definitive test is the **Quantitative spectrophotometric assay**. * **Timing of Test:** Never perform enzyme assays during an acute hemolytic episode, as young RBCs (rich in G6PD) may produce a **false-normal** result [1]. * **Morphology:** Heinz bodies are not visible on Leishman stain; they require **Supravital stains** (e.g., Crystal violet or Methylene blue). **References:** [1] Kumar V, Abbas AK, et al.. Robbins and Cotran Pathologic Basis of Disease. 9th ed. Red Blood Cell and Bleeding Disorders, pp. 642-643. [2] Kumar V, Abbas AK, et al.. Robbins and Cotran Pathologic Basis of Disease. 9th ed. Genetic Disorders, p. 151.
Explanation: ### Explanation The FAB (French-American-British) classification categorizes Acute Lymphoblastic Leukemia (ALL) into three subtypes: L1, L2, and L3. **Why Burkitt’s Lymphoma is correct:** ALL-L3 is now recognized in the WHO classification as **Burkitt-type Leukemia** [1]. These cells are morphologically identical to the cells found in Burkitt’s Lymphoma. They are characterized by: * **Large, uniform cells** with round to oval nuclei [1]. * **Intense basophilic cytoplasm** (deep blue). * **Prominent cytoplasmic vacuolation**, which often contains lipids. * **High mitotic index**, reflecting the aggressive nature of the disease [1]. * **Cytogenetics:** Both typically involve the **t(8;14)** translocation, leading to the overexpression of the *c-MYC* proto-oncogene. **Why the other options are incorrect:** * **Mantle cell lymphoma:** Characterized by small to medium-sized lymphocytes with irregular/cleaved nuclei and a t(11;14) translocation (Cyclin D1). They do not show the intense basophilia or vacuoles of L3 cells. * **Hodgkin’s lymphoma:** Defined by the presence of **Reed-Sternberg (RS) cells** (large, multinucleated cells with "owl-eye" nucleoli) in a polymorphic inflammatory background, which is distinct from the monomorphic blast population in ALL. * **Follicular lymphoma:** Composed of a mixture of centrocytes (cleaved cells) and centroblasts arranged in follicles, typically associated with t(14;18) and BCL-2 expression. **High-Yield Pearls for NEET-PG:** * **L1:** Most common in children; small, uniform cells with scanty cytoplasm. * **L2:** Most common in adults; large, pleomorphic cells with irregular nuclei. * **L3:** Rarest subtype; has the worst prognosis among FAB types. * **Staining:** ALL-L3 vacuoles are **PAS negative** but often **Oil Red O positive** (due to lipid content). According to Robbins, tumor cells in these conditions contain genetic lesions that block differentiation and manifest with signs of marrow failure [1]. **References:** [1] Kumar V, Abbas AK, et al.. Robbins and Cotran Pathologic Basis of Disease. 9th ed. Diseases of White Blood Cells, Lymph Nodes, Spleen, and Thymus, p. 606.
Explanation: **Explanation:** Acute Lymphoblastic Leukemia (ALL) is a heterogeneous group of hematologic malignancies characterized by the clonal proliferation of lymphoid progenitor cells (lymphoblasts) in the bone marrow and peripheral blood [1]. **Why the Correct Answer is Right:** While the majority of ALL cases are of B-cell origin (~85%) or T-cell origin (~15%), the question asks for the **morphological** lineage of ALL as a whole. Under the FAB (French-American-British) classification and WHO guidelines, ALL is defined as a malignancy that can arise from **either** the B-cell or T-cell lineage [1]. Therefore, when discussing ALL as a general entity, it encompasses a **mixed** spectrum of both B-cell and T-cell precursors [1]. **Analysis of Incorrect Options:** * **A. Mature B cell:** Malignancies of mature B cells are classified as B-cell Non-Hodgkin Lymphomas (e.g., CLL/SLL or Burkitt Lymphoma), not ALL. ALL involves "blasts" (immature cells) [1]. * **B. Precursor B cell:** While this is the most common subtype (B-ALL), selecting it exclusively ignores the significant portion of cases that are T-cell derived [1]. * **C. Immature T cell:** This represents T-ALL, which typically presents in adolescent males as a mediastinal mass [1]. Like option B, it is only a subset of the disease. **NEET-PG High-Yield Pearls:** * **Most common subtype:** Pre-B ALL (CD10+ / CALLA positive). * **Cytogenetics:** t(12;21) has a **good prognosis** (common in children); t(9;22) or Philadelphia chromosome has a **poor prognosis** (common in adults) [1]. * **Morphology:** FAB L1 (small, uniform blasts), L2 (large, pleomorphic blasts), L3 (Burkitt-type, vacuolated cytoplasm) [1]. * **Markers:** TdT (Terminal deoxynucleotidyl transferase) is a highly specific marker for lymphoblasts of both B and T lineages. **References:** [1] Kumar V, Abbas AK, et al.. Robbins and Cotran Pathologic Basis of Disease. 9th ed. Diseases of White Blood Cells, Lymph Nodes, Spleen, and Thymus, pp. 596-602.
Explanation: **Explanation:** Polycythemia Vera (PV) is a chronic myeloproliferative neoplasm (MPN) characterized by the autonomous overproduction of red blood cells, almost always driven by a **JAK2 mutation** [1]. **Why Myelofibrosis is the correct answer:** The natural history of PV involves a progression from the "proliferative phase" to the **"spent phase" (Post-polycythemic myelofibrosis)** [2]. Over time, the bone marrow undergoes reactive fibrosis due to the release of fibrogenic cytokines (like TGF-̢̢̢̢̢̢̢̢̢̢̢̢̢̢̢̢̢̢̢̢̢̢̢̢̢̢̢̢̢̢̢̢̢̢̢̢̢̢̢̢̢̢̢̢̢̢̢̢̢̢̢̢̢̢̢̢̢̢̢̢̢̢̢̢̢̢̢̢̢̢̢̢̢̢̢̢̢̢̢̢̢̢̢̢̢̢̢̢̢̢̢̢̢̢̢̢̢̢̢̢̢̢̢̢̢̢̢̢̢̢̢̢̢̢̢̢̢̢̢̢̢̢̢̢̢̢̢̢̢̢̢̢̢̢̢̢̢̢̢̢̢̢̢̢̢̢̢̢̢̢̢̢̢̢̢̢̢̢̢̢̢̢̢̢̢̢̢̢̢̢̢̢̢̢̢̢̢̢̢̢̢̢̢̢̢̢̢̢̢̢̢̢̢̢̢̢̢̢̢̢̢̢̢̢̢̢̢̢̢̢̢̢̢̢̢̢̢̢̢̢̢̢̢̢̢̢̢̢̢̢̢̢̢̢̢̢̢̢̢̢̢̢̢̢̢̢̢̢̢̢̢̢̢̢̢̢̢̢̢̢̢̢̢̢̢̢̢̢̢̢̢̢̢̢̢̢̢̢̢̢̢̢̢̢̢̢̢̢̢̢̢̢̢̢̢̢̢̢̢̢̢̢̢̢̢̢̢̢̢̢̢̢̢̢̢̢̢̢̢̢̢̢̢̢̢̢̢̢̢̢̢̢̢̢̢̢̢̢̢̢̢̢̢̢̢̢̢̢̢̢̢̢̢̢̢̢̢̢̢̢̢̢̢̢̢̢̢̢̢̢̢̢̢̢̢̢̢̢̢̢̢̢̢̢̢̢̢̢̢̢̢̢̢̢̢̢̢̢̢̢̢̢̢̢̢̢̢̢̢̢̢̢̢̢̢̢̢̢̢̢̢̢̢̢̢̢̢̢̢̢̢̢̢̢̢̢̢̢̢̢̢̢̢̢̢̢̢̢̢̢̢̢̢̢̢̢̢̢̢̢̢̢̢̢̢̢̢̢̢̢̢̢̢̢̢̢̢̢̢̢̢̢̢̢̢̢̢̢̢̢̢̢̢̢̢̢̢̢̢̢̢̢̢̢̢̢̢̢̢̢̢̢̢̢̢̢̢̢̢̢̢̢̢̢̢̢̢̢̢̢̢̢̢̢̢̢̢̢̢̢̢̢̢̢̢̢̢̢̢̢̢̢̢̢̢̢̢̢̢̢̢̢̢̢̢̢̢̢̢̢̢̢̢̢̢̢̢̢̢̢̢̢̢̢̢̢̢̢̢̢̢̢̢̢̢̢̢̢̢̢̢̢̢̢̢̢̢̢̢̢̢̢̢̢̢̢̢̢̢̢̢̢̢̢̢̢̢̢̢̢̢̢̢̢̢̢̢̢̢̢̢̢̢̢̢̢̢̢̢̢̢̢̢̢̢̢̢̢̢̢̢̢̢̢̢̢̢̢̢̢̢̢̢̢̢̢̢̢̢̢̢̢̢̢̢̢̢̢̢̢̢̢̢̢̢̢̢̢̢̢̢̢̢̢̢̢̢̢̢̢̢̢̢̢̢̢̢̢̢̢̢̢̢̢̢̢̢̢̢̢̢̢̢̢̢̢̢̢̢̢̢̢̢̢̢̢̢̢̢̢̢̢̢̢̢̢̢̢̢̢̢̢̢̢̢̢̢̢̢̢̢̢̢̢̢̢̢̢̢̢̢̢̢̢̢̢̢̢̢̢̢̢̢̢̢̢̢̢̢̢̢̢̢̢̢̢̢̢̢̢̢̢̢̢̢̢̢̢̢̢̢̢̢̢̢̢̢̢̢̢̢̢̢̢̢̢̢̢̢̢̢̢̢̢̢̢̢̢̢̢̢̢̢̢̢̢̢̢̢̢̢̢̢̢̢̢̢̢̢̢̢̢̢̢̢̢̢̢̢̢̢̢̢̢̢̢̢̢̢̢̢̢̢̢̢̢̢̢̢̢̢̢̢̢̢̢̢̢̢̢̢̢̢̢̢̢̢̢̢̢̢̢̢̢̢̢̢̢̢̢̢̢̢̢̢̢̢̢̢̢̢̢̢̢̢̢̢̢̢̢̢̢̢̢̢̢̢̢̢̢̢̢̢̢̢̢̢̢̢̢̢̢̢̢̢̢̢̢̢̢̢̢̢̢̢̢̢̢̢̢̢̢̢̢̢̢̢̢̢̢̢̢̢̢̢̢̢̢̢̢̢̢̢̢̢̢̢̢̢̢̢̢̢̢̢̢̢̢̢̢̢̢̢̢̢̢̢̢̢̢̢̢̢̢̢̢̢̢̢̢̢̢̢̢̢̢̢̢̢̢̢̢̢̢̢̢̢̢̢̢̢̢̢̢̢̢̢̢̢̢̢̢̢̢̢̢̢̢̢̢̢̢̢̢̢̢̢̢̢̢̢̢̢̢̢̢̢̢̢̢̢̢̢̢̢̢̢̢̢̢̢̢̢̢̢̢̢̢̢̢̢̢̢̢̢̢̢̢̢̢̢̢̢̢̢̢̢̢̢̢̢̢̢̢̢̢̢̢̢̢̢̢̢̢̢̢̢̢̢̢̢̢̢̢̢̢̢̢̢̢̢̢̢̢̢̢̢̢̢̢̢̢̢̢̢̢̢̢̢̢̢̢̢̢̢̢̢̢̢̢̢̢̢̢̢̢̢̢̢̢̢̢̢̢̢̢̢̢̢̢̢̢̢̢̢̢̢̢̢̢̢̢̢̢̢̢̢̢̢̢̢̢̢̢̢̢̢̢̢̢̢̢̢̢̢̢̢̢̢̢̢̢̢̢̢̢̢̢̢̢̢̢̢̢̢̢̢̢̢̢̢̢̢̢̢̢̢̢̢̢̢̢̢̢̢̢̢̢̢̢̢̢̢̢̢̢̢̢̢̢̢̢̢̢̢̢̢̢̢̢̢̢̢̢̢̢̢̢̢̢̢̢̢̢̢̢̢̢̢̢̢̢̢̢̢̢̢̢̢̢̢̢̢̢̢̢̢̢̢̢̢̢̢̢̢̢̢̢̢̢̢̢̢̢̢̢̢̢̢̢̢̢̢̢̢̢̢̢̢̢̢̢̢̢̢̢̢̢̢̢̢̢̢̢̢̢̢̢̢̢̢̢̢̢̢̢̢̢̢̢̢̢̢̢̢̢̢̢̢̢̢̢̢̢̢̢̢̢̢̢̢̢̢̢̢̢̢̢̢̢̢̢̢̢̢̢̢̢̢̢̢̢̢̢̢̢̢̢̢̢̢̢̢̢̢̢̢̢̢̢̢̢̢̢̢̢̢̢̢̢̢̢̢̢̢̢̢̢̢̢̢̢̢̢̢̢̢̢̢̢̢̢̢̢̢̢̢̢̢̢̢̢̢̢̢̢̢̢̢̢̢̢̢̢̢̢̢̢̢̢̢̢̢̢̢̢̢̢̢̢̢̢̢̢̢̢̢̢̢̢̢̢̢̢̢̢̢̢̢̢̢̢̢̢̢̢̢̢̢̢̢̢̢̢̢̢̢̢̢̢̢̢̢̢̢̢̢̢̢̢̢̢̢̢̢̢̢̢̢̢̢̢̢̢̢̢̢̢̢̢̢̢̢̢̢̢̢̢̢̢̢̢̢̢̢̢̢̢̢̢̢̢̢̢̢̢̢̢̢̢̢̢̢̢̢̢̢̢̢̢̢̢̢̢̢̢̢̢̢̢̢̢̢̢̢̢̢̢̢̢̢̢̢̢̢̢̢̢̢̢̢̢̢̢̢̢̢̢̢̢̢̢̢̢̢̢̢̢̢̢̢̢̢̢̢̢̢̢̢̢̢̢̢̢̢̢̢̢̢̢̢̢̢̢̢̢̢̢̢̢̢̢̢̢̢̢̢̢̢̢̢̢̢̢̢̢̢̢̢̢̢̢̢̢̢̢̢̢̢̢̢̢̢̢̢̢̢̢̢̢̢̢̢̢̢̢̢̢̢̢̢̢̢̢̢̢̢̢̢̢̢̢̢̢̢̢̢̢̢̢̢̢̢̢̢̢̢̢̢̢̢̢̢̢̢̢̢̢̢̢̢̢̢̢̢̢̢̢̢̢̢̢̢̢̢̢̢̢̢̢̢̢̢̢̢̢̢̢̢̢̢̢̢̢̢̢̢̢̢̢̢̢̢̢̢̢̢̢̢̢̢̢̢̢̢̢̢̢̢̢̢̢̢̢̢̢̢̢̢̢̢̢̢̢̢̢̢̢̢̢̢̢̢̢̢̢̢̢̢̢̢̢̢̢̢̢̢̢̢̢̢̢̢̢̢̢̢̢̢̢̢̢̢̢̢̢̢̢̢̢̢̢̢̢̢̢̢̢̢̢̢̢̢̢̢̢̢̢̢̢̢̢̢̢̢̢̢̢̢̢̢̢̢̢̢̢̢̢̢̢̢̢̢̢̢̢̢̢̢̢̢̢̢̢̢̢̢̢̢̢̢̢̢̢̢̢̢̢̢̢̢̢̢̢̢̢̢̢̢̢̢̢̢̢̢̢̢̢̢̢̢̢̢̢̢̢̢̢̢̢̢̢̢̢̢̢̢̢̢̢̢̢̢̢̢̢̢̢̢̢̢̢̢̢̢̢̢̢̢̢̢̢̢̢̢̢̢̢̢̢̢̢̢̢̢̢̢̢̢̢̢̢̢̢̢̢̢̢̢̢̢̢̢̢̢̢̢̢̢̢̢̢̢̢̢̢̢̢̢̢̢̢̢̢̢̢̢̢̢̢̢̢̢̢̢̢̢̢̢̢̢̢̢̢̢̢̢̢̢̢̢̢̢̢̢̢̢̢̢̢̢̢̢̢̢̢̢̢̢̢̢̢̢̢̢̢̢̢̢̢̢̢̢̢̢̢̢̢̢̢̢̢̢̢̢̢̢̢̢̢̢̢̢̢̢̢̢̢̢̢̢̢̢̢̢̢̢̢̢̢̢̢̢̢̢̢̢̢̢̢̢̢̢̢̢̢̢̢̢̢̢̢̢̢̢̢̢̢̢̢̢̢̢̢̢̢̢̢̢̢̢̢̢̢̢̢̢̢̢̢̢̢̢̢̢̢̢̢̢̢̢̢̢̢̢̢̢̢̢̢̢̢̢̢̢̢̢̢̢̢̢̢̢̢̢̢̢̢̢̢̢̢̢̢̢̢̢̢̢̢̢̢̢̢̢̢̢̢̢̢̢̢̢̢̢̢̢̢̢̢̢̢̢̢̢̢̢̢̢̢̢̢̢̢̢̢̢̢̢̢̢̢̢̢̢̢̢̢̢̢̢̢̢̢̢̢̢̢̢̢̢̢̢̢̢̢̢̢̢̢̢̢̢̢̢̢̢̢̢̢̢̢̢̢̢̢̢̢̢̢̢̢̢̢̢̢̢̢̢̢̢̢̢̢̢̢̢̢̢̢̢̢̢̢̢̢̢̢̢̢̢̢̢̢̢̢̢̢̢̢̢̢̢̢̢̢̢̢̢̢̢̢̢̢̢̢̢̢̢̢̢̢̢̢̢̢̢̢̢̢̢̢̢̢̢̢̢̢̢̢̢̢̢̢̢̢̢̢̢̢̢̢̢̢̢̢̢̢̢̢̢̢̢̢̢̢̢̢̢̢̢̢̢̢̢̢̢̢̢̢̢̢̢̢̢̢̢̢̢̢̢̢̢̢̢̢̢̢̢̢̢̢̢̢̢̢̢̢̢̢̢̢̢̢̢̢̢̢̢̢̢̢̢̢̢̢̢̢̢̢̢̢̢̢̢̢̢̢̢̢̢̢̢̢̢̢̢̢̢̢̢̢̢̢̢̢̢̢̢̢̢̢̢̢̢̢̢̢̢̢̢̢̢̢̢̢̢̢̢̢̢̢̢̢̢̢̢̢̢̢̢̢̢̢̢̢̢̢̢̢̢̢̢̢̢̢̢̢̢̢̢̢̢̢̢̢̢̢̢̢̢̢̢̢̢̢̢̢̢̢̢̢̢̢̢̢̢̢̢̢̢̢̢̢̢̢̢̢̢̢̢̢̢̢̢̢̢̢̢̢̢̢̢̢̢̢̢̢̢̢̢̢̢̢̢̢̢̢̢̢̢̢̢̢̢̢̢̢̢̢̢̢̢̢̢̢̢̢̢̢̢̢̢̢̢̢̢̢̢̢̢̢̢̢̢̢̢̢̢̢̢̢̢̢̢̢̢̢̢̢̢̢̢̢̢̢̢̢̢̢̢̢̢̢̢̢̢̢̢̢̢̢̢̢̢̢̢̢̢̢̢̢̢̢̢̢̢̢̢̢̢̢̢̢̢̢̢̢̢̢̢̢̢̢̢̢̢̢̢̢̢̢̢̢̢̢̢̢̢̢̢̢̢̢̢̢̢̢̢̢̢̢̢̢̢̢̢̢̢̢̢̢̢̢̢̢̢̢̢̢̢̢̢̢̢̢̢̢̢̢̢̢̢̢̢̢̢̢̢̢̢̢̢̢̢̢̢̢̢̢̢̢̢̢̢̢̢̢̢̢̢̢̢̢̢̢̢̢̢̢̢̢̢̢̢̢̢̢̢̢̢̢̢̢̢̢̢̢̢̢̢̢̢̢̢̢̢̢̢̢̢̢̢̢̢̢̢̢̢̢̢̢̢̢̢̢̢̢̢̢̢̢̢̢̢̢̢̢̢̢̢̢̢̢̢̢̢̢̢̢̢̢̢̢̢̢̢̢̢̢̢̢̢̢̢̢̢̢̢̢̢̢̢̢̢̢̢̢̢̢̢̢̢̢̢̢̢̢̢̢̢̢̢̢̢̢̢̢̢̢̢̢̢̢̢̢̢̢̢̢̢̢̢̢̢̢̢̢̢̢̢̢̢̢̢̢̢̢̢̢̢̢̢̢̢̢̢̢̢̢̢̢̢̢̢̢̢̢̢̢̢̢̢̢̢̢̢̢̢̢̢̢̢̢̢̢̢̢̢̢̢̢̢̢̢̢̢̢̢̢̢̢̢̢̢̢̢̢̢̢̢̢̢̢̢̢̢̢̢̢̢̢̢̢̢̢̢̢̢̢̢̢̢̢̢̢̢̢̢̢̢̢̢̢̢̢̢̢̢̢̢̢̢̢̢̢̢̢̢̢̢̢̢̢̢̢̢̢̢̢̢̢̢̢̢̢̢̢̢̢̢̢̢̢̢̢̢̢̢̢̢̢̢̢̢̢̢̢̢̢̢̢̢̢̢̢̢̢̢̢̢̢̢̢̢̢̢̢̢̢̢̢̢̢̢̢̢̢̢̢̢̢̢̢̢̢̢̢̢̢̢̢̢̢̢̢̢̢̢̢̢̢̢̢̢̢̢̢̢̢̢̢̢̢̢̢̢̢̢̢̢̢̢̢̢̢̢̢̢̢̢̢̢̢̢̢̢̢̢̢̢̢̢̢̢̢̢̢̢̢̢̢̢̢̢̢̢̢̢̢̢̢̢̢̢̢̢̢̢̢̢̢̢̢̢̢̢̢̢̢̢̢̢̢̢̢̢̢̢̢̢̢̢̢̢̢̢̢̢̢̢̢̢̢̢̢̢̢̢̢̢̢̢̢̢̢̢̢̢̢̢̢̢̢̢̢̢̢̢̢̢̢̢̢̢̢̢̢̢̢̢̢̢̢̢̢̢̢̢̢̢̢̢̢̢̢̢̢̢̢̢̢̢̢̢̢̢̢̢̢̢̢̢̢̢̢̢̢̢̢̢̢̢̢̢̢̢̢̢̢̢̢̢̢̢̢̢̢̢̢̢̢̢̢̢̢̢̢̢̢̢̢̢̢̢̢̢̢̢̢̢̢̢̢̢̢̢̢̢̢̢̢̢̢̢̢̢̢̢̢̢̢̢̢̢̢̢̢̢̢̢̢̢̢̢̢̢̢̢̢̢̢̢̢̢̢̢̢̢̢̢̢̢̢̢̢̢̢̢̢̢̢̢̢̢̢̢̢̢̢̢̢̢̢̢̢̢̢̢̢̢̢̢̢̢̢̢̢̢̢̢̢̢̢̢̢̢̢̢̢̢̢̢̢̢̢̢̢̢̢̢̢̢̢̢̢̢̢̢̢̢̢̢̢̢̢̢̢̢̢̢̢̢̢̢̢̢̢̢̢̢̢̢̢̢̢̢̢̢̢̢̢̢̢̢̢̢̢̢̢̢̢̢̢̢̢̢̢̢̢̢̢̢̢̢̢̢̢̢̢̢̢̢̢̢̢̢̢̢̢̢̢̢̢̢̢̢̢̢̢̢̢̢̢̢̢̢̢̢̢̢̢̢̢̢̢̢̢̢̢̢̢̢̢̢̢̢̢̢̢̢̢̢̢̢̢̢̢̢̢̢̢̢̢̢̢̢̢̢̢̢̢̢̢̢̢̢̢̢̢̢̢̢̢̢̢̢̢̢̢̢̢̢̢̢̢̢̢̢̢̢̢̢̢̢̢̢̢̢̢̢̢̢̢̢̢̢̢̢̢̢̢̢̢̢̢̢̢̢̢̢̢̢̢̢̢̢̢̢̢̢̢̢̢̢̢̢̢̢̢̢̢̢̢̢̢̢̢̢̢̢̢̢̢̢̢̢̢̢̢̢̢̢̢̢̢̢̢̢̢̢̢̢̢̢̢̢̢̢̢̢̢̢̢̢̢̢̢̢̢̢̢̢̢̢̢̢̢̢̢̢̢̢̢̢̢̢̢̢̢̢̢̢̢̢̢̢̢̢̢̢̢̢̢̢̢̢̢̢̢̢̢̢̢̢̢̢̢̢̢̢̢̢̢̢̢̢̢̢̢̢̢̢̢̢̢̢̢̢̢̢̢̢̢̢̢̢̢̢̢̢̢̢̢̢̢̢̢̢̢̢̢̢̢̢̢̢̢̢̢̢̢̢̢̢̢̢̢̢̢̢̢̢̢̢̢̢̢̢̢̢̢̢̢̢̢̢̢̢̢̢̢̢̢̢̢̢̢̢̢̢̢̢̢̢̢̢̢̢̢̢̢̢̢̢̢̢̢̢̢̢̢̢̢̢̢̢̢̢̢̢̢̢̢̢̢̢̢̢̢̢̢̢̢̢̢̢̢̢̢̢̢̢̢̢̢̢̢̢̢̢̢̢̢̢̢̢̢̢̢̢̢̢̢̢̢̢̢̢̢̢̢̢̢̢̢̢̢̢̢̢̢̢̢̢̢̢̢̢̢̢̢̢̢̢̢̢̢̢̢̢̢̢̢̢̢̢̢̢̢̢̢̢̢̢̢̢̢̢̢̢̢̢̢̢̢̢̢̢̢̢̢̢̢̢̢̢̢̢̢̢̢̢̢̢̢̢̢̢̢̢̢̢̢̢̢̢̢̢̢̢̢̢̢̢̢̢̢̢̢̢̢̢̢̢̢̢̢̢̢̢̢̢̢̢̢̢̢̢̢̢̢̢̢̢̢̢̢̢̢̢̢̢̢̢̢̢̢̢̢̢̢̢̢̢̢̢̢̢̢̢̢̢̢̢̢̢̢̢̢̢̢̢̢̢̢̢̢̢̢̢̢̢̢̢̢̢̢̢̢̢̢̢̢̢̢̢̢̢̢̢̢̢̢̢̢̢̢̢̢̢̢̢̢̢̢̢̢̢̢̢̢̢̢̢̢̢̢̢̢̢̢̢̢̢̢̢̢̢̢̢̢̢̢̢̢̢̢̢̢̢̢̢̢̢̢̢̢̢̢̢̢̢̢̢̢̢̢̢̢̢̢̢̢̢̢̢̢̢̢̢̢̢̢̢̢̢̢̢̢̢̢̢̢̢̢̢̢̢̢̢̢̢̢̢̢̢̢̢̢̢̢̢̢̢̢̢̢̢̢̢̢̢̢̢̢̢̢̢̢̢̢̢̢̢̢̢̢̢̢̢̢̢̢̢̢̢̢̢̢̢̢̢̢̢̢̢̢̢̢̢̢̢̢̢̢̢̢̢̢̢̢̢̢̢̢̢̢̢̢̢̢̢̢̢̢̢̢̢̢̢̢̢̢̢̢̢̢̢̢̢̢̢̢̢̢̢̢̢̢̢̢̢̢̢̢̢̢̢̢̢̢̢̢̢̢̢̢̢̢̢̢̢̢̢̢̢̢̢̢̢̢̢̢̢̢̢̢̢̢̢̢̢̢̢̢̢̢̢̢̢̢̢̢̢̢̢̢̢̢̢̢̢̢̢̢̢̢̢̢̢̢̢̢̢̢̢̢̢̢̢̢̢̢̢̢̢̢̢̢̢̢̢̢̢̢̢̢̢̢̢̢̢̢̢̢̢̢̢̢̢̢̢̢̢̢̢̢̢̢̢̢̢̢̢̢̢̢̢̢̢̢̢̢̢̢̢̢̢̢̢̢̢̢̢̢̢̢̢̢̢̢̢̢̢̢̢̢̢̢̢̢̢̢̢̢̢̢̢̢̢̢̢̢̢̢̢̢̢̢̢̢̢̢̢̢̢̢̢̢̢̢̢̢̢̢̢̢̢̢̢̢̢̢̢̢̢̢̢̢̢̢̢̢̢̢̢̢̢̢̢̢̢̢̢̢̢̢ **Why other options are incorrect:** * **Infection:** While PV involves increased white cells, they are functional. Infection is more characteristic of leukopenic states or hematologic malignancies like Acute Myeloid Leukemia (AML). * **Hemolysis:** PV is a disorder of overproduction, not destruction. Anemia in PV only occurs during the late spent phase or due to iron deficiency from therapeutic phlebotomy. * **Renal failure:** While hyperuricemia (due to high cell turnover) can lead to urate nephropathy, it is not a primary or "common" defining complication compared to the inevitable progression to fibrosis or thrombosis. **High-Yield Clinical Pearls for NEET-PG:** * **JAK2V617F Mutation:** Present in >95% of PV cases [1]. * **Spent Phase:** Characterized by teardrop RBCs (dacrocytes) on peripheral smear and a "dry tap" on bone marrow aspiration [3]. * **Thrombosis:** The most common cause of morbidity and mortality in PV (Budd-Chiari syndrome is a classic association). * **Leukemic Transformation:** PV can transform into AML, though this is less common than progression to myelofibrosis. * **Erythropoietin (EPO) Levels:** Characteristically **low** in PV (helps differentiate from secondary polycythemia) [1]. **References:** [1] Cross SS. Underwood's Pathology: A Clinical Approach. 6th ed. Common Clinical Problems From Blood And Bone Marrow Disease, pp. 614-615. [2] Kumar V, Abbas AK, et al.. Robbins and Cotran Pathologic Basis of Disease. 9th ed. Diseases of White Blood Cells, Lymph Nodes, Spleen, and Thymus, pp. 626-627. [3] Kumar V, Abbas AK, et al.. Robbins and Cotran Pathologic Basis of Disease. 9th ed. Diseases of White Blood Cells, Lymph Nodes, Spleen, and Thymus, pp. 628-629.
Explanation: **Explanation:** The correct answer is **Glycoprotein 1b (Gp1b)**. This question tests the fundamental steps of primary hemostasis, specifically **platelet adhesion**. 1. **Why Gp1b is correct:** When a blood vessel is injured, subendothelial collagen is exposed. **von Willebrand Factor (vWF)** acts as a molecular bridge, binding to the exposed collagen on one side and to the **Gp1b-IX-V complex** on the platelet surface on the other [1], [2]. This interaction is crucial for the initial tethering of platelets to the site of injury under high shear stress [1]. 2. **Why the other options are incorrect:** * **ADP:** This is an agonist stored in platelet **delta (dense) granules** [1]. It is released during platelet activation to recruit more platelets and induce the expression of GpIIb/IIIa receptors (aggregation), but it is not a binding site for vWF. * **Factor VIII:** vWF acts as a carrier protein for Factor VIII in the circulation, protecting it from degradation [2]. However, Factor VIII does not mediate the binding of vWF to platelets. * **Thromboxane A2 (TXA2):** This is a potent vasoconstrictor and platelet activator synthesized via the COX-1 pathway. Like ADP, it aids in aggregation but not in the initial vWF-mediated adhesion. **High-Yield Clinical Pearls for NEET-PG:** * **Bernard-Soulier Syndrome:** A deficiency of **Gp1b** [2]. Characterized by thrombocytopenia and **giant platelets**. On peripheral smear, platelets are as large as RBCs. * **von Willebrand Disease (vWD):** The most common inherited bleeding disorder; caused by a deficiency or dysfunction of vWF. * **Ristocetin Cofactor Assay:** Ristocetin induces platelet agglutination by activating vWF to bind Gp1b. * **GpIIb/IIIa:** The receptor for **fibrinogen**, responsible for platelet-platelet **aggregation** (deficient in Glanzmann Thrombasthenia) [2]. **References:** [1] Kumar V, Abbas AK, et al.. Robbins and Cotran Pathologic Basis of Disease. 9th ed. Hemodynamic Disorders, Thromboembolic Disease, and Shock, p. 128. [2] Kumar V, Abbas AK, et al.. Robbins and Cotran Pathologic Basis of Disease. 9th ed. Red Blood Cell and Bleeding Disorders, pp. 668-670.
Explanation: ***t(11;14)*** - This translocation involves **CCND1 gene** overexpression and is associated with **standard/favorable risk** in multiple myeloma prognostic stratification. - Patients with t(11;14) typically have **better overall survival** and **response to treatment** compared to other high-risk translocations. *t(14;16)* - This translocation involves the **MAF oncogene** and is classified as **high-risk** by International Myeloma Working Group (IMWG) criteria. - Associated with **poor prognosis**, **aggressive disease course**, and **shorter overall survival** in multiple myeloma patients. *t(4;14)* - This translocation results in **FGFR3** and **MMSET gene** dysregulation and is considered **high-risk** cytogenetics. - Patients typically have **poor prognosis** with **reduced progression-free survival** and **overall survival** rates. *Loss of 13q14* - This chromosomal deletion is associated with **intermediate to poor prognosis** when present as monosomy 13 or del(13q). - Often occurs in conjunction with other **high-risk cytogenetic abnormalities** and contributes to **adverse outcomes** in multiple myeloma.
Explanation: ### Explanation **Correct Option: C. Paroxysmal Nocturnal Hemoglobinuria (PNH)** PNH is an acquired clonal hematopoietic stem cell disorder caused by a somatic mutation in the **PIGA gene**, leading to a deficiency of GPI-anchored proteins (like CD55 and CD59). Because the defect occurs at the level of the **multipotent stem cell**, PNH is considered a "pre-leukemic" state. Approximately 2–5% of PNH cases transform into **Acute Myeloid Leukemia (AML)** or Myelodysplastic Syndrome (MDS). This transformation occurs due to the inherent genomic instability of the mutant clone and the selective pressure within a hypocellular bone marrow environment. **Analysis of Incorrect Options:** * **A. Microangiopathic Hemolytic Anemia (MAHA):** This is a mechanical hemolytic process (e.g., TTP, HUS, DIC) caused by RBC fragmentation in small vessels. It is an acquired peripheral destruction disorder and does not involve the bone marrow stem cells or carry malignant potential. * **B. Sideroblastic Anemia:** While some *acquired* forms (like RARS) are part of MDS and can progress to AML, the term generally refers to a defect in heme synthesis. In the context of this question, PNH is the classic "high-yield" association for stem cell transformation. * **C. Megaloblastic Anemia:** This is caused by Vitamin B12 or Folate deficiency leading to impaired DNA synthesis. It is a reversible metabolic defect and does not lead to leukemia. **NEET-PG High-Yield Pearls:** * **PNH Triad:** Hemolytic anemia (intravascular), Pancytopenia, and Venous thrombosis (most common cause of death) [1]. * **Gold Standard Test:** Flow cytometry for CD55/CD59 negative RBCs and WBCs (FLAER assay is highly sensitive) [1]. * **Bone Marrow Link:** PNH often arises in the setting of **Aplastic Anemia** (the "PNH-Aplastic Anemia syndrome"). * **Treatment:** Eculizumab (a monoclonal antibody against Complement C5). **References:** [1] Kumar V, Abbas AK, et al.. Robbins and Cotran Pathologic Basis of Disease. 9th ed. Red Blood Cell and Bleeding Disorders, pp. 650-651.
Anemias: Classification and Approach
Practice Questions
Hemolytic Anemias
Practice Questions
Myeloproliferative Neoplasms
Practice Questions
Myelodysplastic Syndromes
Practice Questions
Acute Leukemias
Practice Questions
Chronic Leukemias
Practice Questions
Lymphomas and Lymphoid Neoplasms
Practice Questions
Plasma Cell Disorders
Practice Questions
Bleeding Disorders
Practice Questions
Thrombotic Disorders
Practice Questions
Get full access to all questions, explanations, and performance tracking.
Start For Free